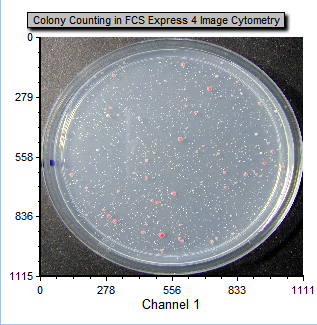

Image Cytometry Applications Examples
FCS Express is one of the premier tools for analysis and reporting of your image cytometry data. The application examples below illustrate how FCS Express can be used to create stunning reports while easily performing complex analysis.
Jump to Flow Cytometry Applications.
Would you like to see your Image Cytometry Application in this list? If so, please email us at support@denovosoftware.com.
| The award-winning Invitrogen Attune CytPix Flow Cytometer combines acoustic focusing with a high-speed brightfield camera for simultaneous high throughput flow cytometry and high resolution brightfield imaging. De Novo Software has continued to collaborate with the Thermo Scientific to support both .FCS file and .ACS file exports from the CytPix so FCS Express users can continue to move from raw data to results while maintaining access to images and linking between images, plots, gates, and statistics. | 
|
The apoptosis analysis example below outlines an approach to evaluating and assessing apoptosis while working with data from the CytPix, including images. In the example layout, users will find the ability to confirm gating strategies by reviewing images via Data Grids as well as displaying representative images of populations as part of the analysis strategy. The analysis example incorporates a comparison of extended parameters created from the Attune Cytometric Software which have the capability to provide data to confirm singlets with cell count (Particle Count) and morphology features such as roundness (Circularity), size (Area Square), shape (Eccentricity) and complexity (Entropy) to standard parameters. Using image analysis features created by Attune Cytometric software for morphometric parameters like the particle count allows users to quickly and accurately identify populations of interest and confirm gating strategies.
View example images below or download the example layout generated from an Attune CytPix dataset.
Would you like to see your Image Cytometry Application in this list? If so, please email us at support@denovosoftware.com.
Publications For Image Cytometry Using FCS Express
NucleoCounter is a registered trademark of Chemometec.
NC-3000 is a trademark of Chemometec.
Cellometer is a registered trademark of Nexcelom.
Opera is a registered trademark of PerkinElmer






 Cellometer Vision was developed to count total cells and identify FITC-annexin-V positive apoptotic cells based on the microscopic and fluorescence characteristics of the cell sample. Detection typically takes less than 60 seconds and only requires 20µl of cell sample. Cell images and all analysis data, including cell size distribution histograms, can be saved for documentation. Data can also be easily exported to FCS Express and utilize the Image Cytometry features for further analysis.
Cellometer Vision was developed to count total cells and identify FITC-annexin-V positive apoptotic cells based on the microscopic and fluorescence characteristics of the cell sample. Detection typically takes less than 60 seconds and only requires 20µl of cell sample. Cell images and all analysis data, including cell size distribution histograms, can be saved for documentation. Data can also be easily exported to FCS Express and utilize the Image Cytometry features for further analysis.
 You have carefully planned, implemented, and imaged your multi color in-situ staining experiment resulting in large montaged images containing tens or even hundreds of thousands of cells...now what? After segmentation with CellProfiler, FCS Express can handle these large data sets much like a multi color flow cytometry experiment but with the added advantage of spacial resolution and the ability quickly move from the population level down to individual cells and images.
You have carefully planned, implemented, and imaged your multi color in-situ staining experiment resulting in large montaged images containing tens or even hundreds of thousands of cells...now what? After segmentation with CellProfiler, FCS Express can handle these large data sets much like a multi color flow cytometry experiment but with the added advantage of spacial resolution and the ability quickly move from the population level down to individual cells and images.




 Data from the Amnis IDEAS software package can be exported for use in FCS Express. Use FCS Express to navigate between plots and images in real time, create custom statistics, and export directly to PowerPoint for quick and easy presentation of your data.
Data from the Amnis IDEAS software package can be exported for use in FCS Express. Use FCS Express to navigate between plots and images in real time, create custom statistics, and export directly to PowerPoint for quick and easy presentation of your data.










 Download the PDF version of the layout:
Download the PDF version of the layout: 










 FCS Express can be used to organize, analyze, and get results from any imaging experiment. By using CellProfiler to segment your images you can analyze the simplest single image experiments to complex multi-time point and multi-color assays in FCS Express. See for yourself while learning FCS Express with our
FCS Express can be used to organize, analyze, and get results from any imaging experiment. By using CellProfiler to segment your images you can analyze the simplest single image experiments to complex multi-time point and multi-color assays in FCS Express. See for yourself while learning FCS Express with our 
 FCS Express can also be used in conjunction with ImageJ to get data from your images. By using ImageJ to segment your images and
FCS Express can also be used in conjunction with ImageJ to get data from your images. By using ImageJ to segment your images and 







 Generating large data sets to look at multiple tumor core histology sections has become relatively easy with new imaging technology although bottle necks usually occur during the analysis step. Now with FCS Express by using the Image Cytometry features making sense of the data and analyzing it quickly is made easy with the use of interactive plots and batch analysis.
Generating large data sets to look at multiple tumor core histology sections has become relatively easy with new imaging technology although bottle necks usually occur during the analysis step. Now with FCS Express by using the Image Cytometry features making sense of the data and analyzing it quickly is made easy with the use of interactive plots and batch analysis.

 Histological sections with tiled images (i.e., contiguous fields of view) which have been segmented in ImageJ can be exported and stitched together in FCS Express, using
Histological sections with tiled images (i.e., contiguous fields of view) which have been segmented in ImageJ can be exported and stitched together in FCS Express, using

Colony counting can be a tedious task at best. Let FCS Express with Image Cytometry features do the counting and classification for you so you can spend more time getting to results. Explore the layout using the free
Colony counting can be a tedious task at best. Let FCS Express with Image Cytometry features do the counting and classification for you so you can spend more time getting to results. Explore the layout using the free 



 The
The 
